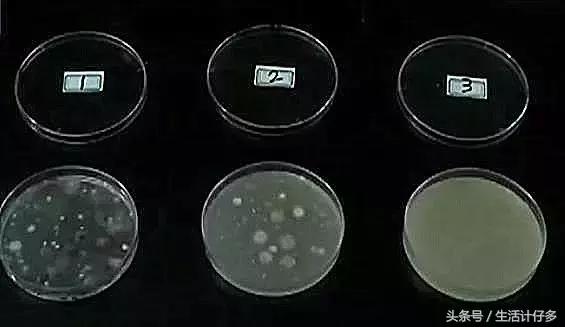
回南天的霉菌用什么擦洗,回南天霉菌怎么消

昨天,计仔君很贴心地教大家回南天祛湿的计仔(请看我们发的回南天喝了这碗汤,开胃又祛湿【专家强推食疗攻略】)。今天再跟你们讲一讲如何让我们的生活用品安全度过回南天~
身为广东人,计仔君觉得一年只有三个季节:夏天+回南天+冬天!
回南天什么概念?衣服不干之后就——发霉;家里浴室总是湿漉漉的结果就——发霉;开窗通风,一不小心墙面凝结了小水珠就——发霉……

因为潮湿的天气,导致家里发霉的现象数不胜数,家里墙角发霉更是屡见不鲜,长时间收纳的衣物被褥发霉,也都非常常见。


你这么霉,霉,你这么霉,霉,你这么霉……
不过,发霉虽然可怕,但也不是没有办法消灭它的,想要抵抗发霉,专家说我们需要的只是家中厨房里一种普通的调味料~

“其实很简单,只要把平时吃的芥末酱和水相互调开,将这个混合液喷洒在墙壁上就能防止霉斑生长。”
芥末?!?!
能抑制霉菌斑的生长!?

想不到吧,就是这种我们在吃寿司或者拌凉菜时常常用到的芥末酱还有如此功效。

不过,食用芥末为什么能够抑制霉菌呢?
首先,计仔君要告诉大家霉菌到底是什么东西~
霉菌是丝状真菌的俗称,意即"发霉的真菌",它们往往能形成分枝繁茂的菌丝体,但又不象蘑菇那样产生大型的子实体。在潮湿温暖的地方,很多物品上长出一些肉眼可见的绒毛状、絮状或蛛网状的菌落,那就是霉菌。

(*@ο@*) 哇~好吓人
这么看霉菌似乎很顽强呢,芥末君能够“打败”它吗?刘博士给计仔君做了一个小实验,你们看完就知道了!
实验芥末水能否抑制霉菌生长
三个器皿分别培养同种类型的霉菌,再倒入器皿中。
1号器皿:无添加其他物质
2号器皿:添加浓度为1%的芥末水
3号器皿:添加浓度为3%的芥末水
放置在空气中每一周后····
结果
1号器皿:大量细菌
2号器皿:少量细菌
3号器皿:看不到霉菌的痕迹

专家称,这是因为芥末中含有一种物质叫做辛辣烯丙基,这种物质是具有杀菌的作用,因此能够有效的抑制霉菌生长。
看来这芥末确实可以用来抑制霉菌的生长。那在生活中,我们该怎么利用它来抑制细菌呢?
芥末抑菌小妙招
准备一段约为4-5厘米长的芥末和200ML 左右的水,大概就等于平时家里一杯玻璃杯的分量,混合均匀,等芥末在水里充分溶解之后,倒入普通的喷壶内。

最后只需要在容易生长霉菌的地方喷洒,每两个星期喷一次,就可以防止霉斑生长啦!

除了这个方法,我们也可以用其他的一些有消毒作用的东西(例如浓度为70%的酒精)来做霉菌的清洗。但要想去除家里的霉菌,我们除了要消毒擦洗,主要的还是要不给霉菌提供生长的环境。
家庭防霉要点
1

2

3

4

计仔君在这里再给大家分享几个去霉小妙招!
如果家里的墙纸发霉了……

● 酒精或84消毒液:壁纸上的霉菌刚开始滋长成较小一团,可抹布蘸取5%浓度的酒精进行擦拭,1:24比例的84消毒液同样有此消毒效果。
● 干燥产品吸湿:去霉的同时还需使用除湿和干燥产品,*管双**齐下杜绝霉菌滋生。大空间可选用专业*湿机除**或具有除湿功能的空气净化器,若空间较小,可在长霉处附近摆放用布袋装上的干茶叶,除湿去霉味。
如果家里的木地板发霉了……

● 牙膏:针对地板表面轻微霉斑,可利用牙膏将其打磨去除,打磨后用抹布擦干,并为地板涂上专用的木材保护剂。
● 漂白水:对于地板表面少量霉斑,可以及时用温性的漂白水以1:3的比例与水混合稀释,用柔软的抹布蘸上漂白溶液擦拭。
用布料或麻袋裹装生石灰或木炭后放在发霉的家具旁边,这两者都很吸潮。

家具上出现霉菌之后产生的不好问的霉味也是我们的苦恼。只要在有霉味的地方放块香皂或装满晾干的茶叶渣的纱布包,有助消除霉味。

现在,你对于打败霉菌是不是增强了很多信心呢?

回南天不用怕!跟着计仔君的步伐,让我们远离霉,变更美!
